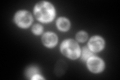
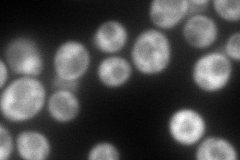
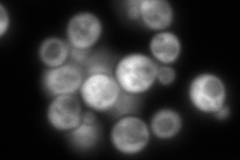
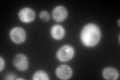

View description
Alpha subunit of fatty acid synthetase, which catalyzes the synthesis of long-chain saturated fatty acids; contains beta-ketoacyl reductase and beta-ketoacyl synthase activities; phosphorylated
Localization:
Intensity:
Fold change:
Significance:
-
C’ GFP library in SD
cytosol519.37 -
N' NOP1pr-GFP in SD

cytosol417.988 -
N' TEF2pr-mCherry in SD
cytosol168.951 -
N' NATIVEpr-GFP in SD
cytosol379.52 -
N' TEF2pr-VC and Cyto-VN in SD

#N/A0 -
C’ GFP library in SD+DTT

cytosol798.471.53Yes -
C’ GFP library in SD+H2O2

cytosol414.920.79No -
C’ GFP library in Starvation Media
cytosol387.450.74No -
C’ GFP library on the background of Pup2-DaMP

cytosol -
C’ GFP library on the background of CCT mutant

cytosol502.8780.968227No
